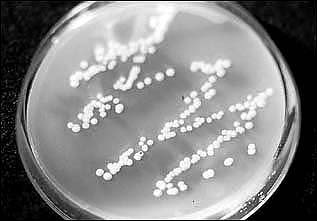

Der Zucker, der Zucker!
Die am häufigsten geäußerte Ernährungsempfehlung bei Befall mit Candida
albicans ist die, Zucker zu meiden, um damit dem Pilz quasi die
Lebensgrundlage zu entziehen, denn Pilze leben von Kohlenhydraten.
Von physiologischer Seite betrachtet dürfte im Dickdarm eigentlich gar kein
Zucker mehr ankommen, da dieser schon im Dünndarm resorbiert wird.
Weiter sind im Dickdarm auch noch Bakterien, die weitaus besser an das
Milieu angepaßt sind als Candida albicans und Co.
Da es den Pilzbefall im Dickdarm nun aber gibt, muß es dort auch eine
Nahrungsquelle für sie geben.
Sie können nämlich auch komplexe Kohlenhydrate, wie z.B. Stärke,
verwerten, besonders "gut" gedeihen sie, wenn sie Einfach- und
Zweifachzucker verwenden können. Diese sind z.B. enthalten in:
- Haushaltszucker, Süßwaren, Honig,
- Diabetikerzucker (Fructose),
- Obst, Obstkonserven, Trockenobst
- Rübensirup,
- Dicksäfte, Limonaden
- Bier, Wein, Likör etc.
Eine Ausnahme bildet der Milchzucker (Laktose). Diesen Zucker können die
Hefen nicht verstoffwechseln. Da Lactose gleichzeitig eine gute
Nahrungsquelle für die im Darm erwünschten Lactobazillen darstellt, kann
sie sogar helfen, das aus dem Lot gebrachte Gleichgewicht wieder zu
korrigieren.
Manche Ratgeber gehen sogar soweit, Kohlenhydrate ganz zu verbieten.
Dies ist mit Sicherheit nicht nur unsinnig, sondern, allein schon wegen des
damit drastisch ansteigenden Anteils von Fett und Eiweiß, sogar
gesundheitsschädigend. Würden keine Kohlenhydrate mehr gegessen,
fände auch keine Aufnahme von Ballaststoffen mehr statt. Diese sind aber
bei der Pilzbekämpfung sehr hilfreich, da sie im Darm quasi wie ein Besen
wirken. In gequollenem Zustand (Immer auch genügend Flüssigkeit trinken!)
dehnen sie die Falten der Darmwand und fegen Pilznester sozusagen aus.
Außerdem bieten sie Medikamenten eine optimale Wirkfläche.
Stichwort Medikamente
Bei der Therapie einer Candidose ist die Einnahme von Medikamenten
unerläßlich. Der Pilz läßt sich nicht aushungern. Ganz im Gegenteil!
Findet der Pilz keine Nahrung, durchwandert er die Darmschleimhaut und kann sich
aber die Blutgefäße auch auf Organen niederlassen. Der Pilz reagiert also
aus seiner Sicht völlig richtig.